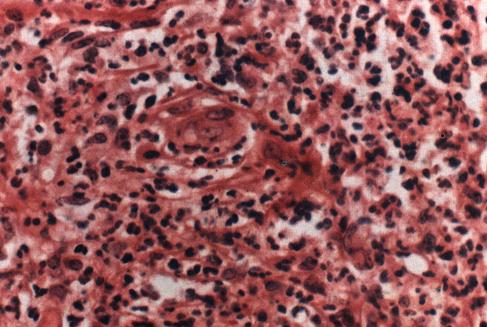

麻风反应的病理
麻风病是一个慢性炎症过程。在此过程中所呈现的某些在病因和发病学上直接同本病相关的急性炎症现象,即称为麻风反应。它不是疾病的主体,而只是从属于疾病主体病理过程的免疫合并症。按导致麻风反应的免疫机制的不同,可将其分为下列两大类型。
1.I型反应 为一种细胞免疫反应,即由免疫可识别的ML抗原所诱导和触发的迟发性超敏反应。此型反应常发生于免疫状态不稳定的BT-BL及少数LLs型病人。由于患者的基础免疫状态和治疗情况的不同,以及抗原暴露与被识别早迟的差异,此型反应常伴有超敏性水平或分类的变动,故可有升级、降级和稳态反应之分。
2.Ⅱ型反应 为一组属于体液免疫范畴的反应。其中包括ENL、露西奥(Lucio)现象和加剧反应。前两种反应是由抗原、抗体和补体组成的免疫复合物介导的。后者被认为是由反应素所介导的。此型反应常见于LL及少数BL型病人。
一、Ⅰ型反应
早期表现为肉芽肿内及其周围和真皮浅层出现轻微的弥漫性细胞外水肿和真皮内弥漫性成纤维细胞增生。这种变化与肉芽肿本身无关。以后,上述变化程度随着反应的发展而发展,各例患者变化程度差异很大。可以出现异物巨细胞。由于水肿的发展,细胞内也呈水肿,以致肉芽肿浸润稀散,上皮样细胞水化样变性,胞浆内出现空泡,有可能和瘤型麻风空泡化的巨噬细胞不易鉴别,但它们不含抗酸菌。严重反应的重要特点是肉芽肿的解体和离散,甚或液化坏死并形成溃疡。有时存在小的多形核白细胞聚集,但不像ENL那样,它们是和上皮样细胞相伴随的。在反应的早期和急性阶段不可能确定这个反应是升级、降级,还是不升不降。肉芽肿最终会按反应发展的状况而重新形成。如果是升级反应,则出现明显的上皮样细胞肉芽肿和大的郎罕氏巨细胞(也有异物巨细胞);在皮肤小神经束内可以见到结核样肉芽肿形成,甚至干酪样坏死。如果出现明显的表皮受侵蚀以及纤维蛋白样坏死,都表明是强有力的升级反应,后者更表明是TTs,并继以纤维化。如果是降级反应,则最终发展为下一级甚至两级的病理图像(照片9)。

照片9 Ⅰ型反应
真皮及结核样浸润灶内明显水肿,细胞间分离。淋巴管扩张。
如有反应前后的活检比较,更有利于判定反应后的降、升级的变化。
二、Ⅱ型反应
(一)麻风性结节性红斑
早期表现为真皮浅层的微血管扩张充血,组织水肿;真皮深部及皮下脂肪层的血管及退化性的泡沫细胞小灶周围,显示主要由嗜中性白细胞所组成的急性炎症浸润,并掺杂一些淋巴细胞及少数嗜伊红细胞。可有微脓肿形成。尔后,随着时间的推移,嗜中性白细胞的数目逐渐减少,淋巴细胞和组织细胞的比率相应升高。及至反应后期,通常仅显示主要由组织细胞、淋巴细胞和一些浆细胞所组成的慢性炎症浸润,并可见成纤维细胞增生,甚或纤维化。有时可以观察到同反应程期一致的急性变应性血管炎或慢性增生性的血管炎现象。细菌通常稀少,且呈颗粒状(照片10)。
照片10 结节性红斑反应(ENL)
小血管壁及浸润内有大量多核白细胞浸润。
(二)Lucio现象
仅见于中美洲(主要是墨西哥)及其临近地区的弥漫性瘤型麻风病人。R.Lucio于1852年首先记述了这一反应现象,故名。其临床表现为成批发生的出血坏死性红斑。在组织学上,除真皮内存在一些小肉芽肿或孤立散在的巨噬细胞外,还存在导致皮肤出血和梗死的多发性急性闭塞性血管炎,毛细血管内含有大量的细菌。真皮深部较大的肉芽肿团块周围显示与ENL大致相同的急性炎症改变。
(三)加剧反应
为一种发生于高度活动的瘤型病损的局限性反应。其受累位置是肉芽肿的中心或表皮下的浅表真皮。早期病损显示同巨噬细胞变性相关的嗜中性白细胞浸润。严重的进行性病损则显示浅表淋巴管扩张,反应中心呈现明显的间质水肿,巨噬细胞排列松散,甚或有出血、坏死以及区域性的嗜伊红性变性物质积聚;有时还可见有明显的坏死性血管炎及较多的核尘。反应位置浅表者,可导致大疱和溃疡形成。病损内含有大量的活菌。
- I015325 解放上海的故事是什么意思
- I015326 西双版纳密林的趣闻是什么意思
- I015331 第一次环球航行是什么意思
- I015332 为人类增添欢乐是什么意思
- I015339 马可·波罗是什么意思
- I015340 林则徐的故事是什么意思
- I015342 李白的故事是什么意思
- I015350 科学家故事100个是什么意思
- I015353 将军从这里起步是什么意思
- I015354 打开地下宝库是什么意思
- I015355 郭亮不死是什么意思
- I015363 大地的儿子——周恩来的故事是什么意思
- I015364 彭总在中南海是什么意思
- I015365 中国近代科学先驱徐光启是什么意思
- I015371 森林旅行记是什么意思
- I015372 海龟飞上天是什么意思
- I015373 自然交响曲的知音竺可桢是什么意思
- I015381 西探聚宝盆是什么意思
- I015382 骨石生涯是什么意思
- I015383 中国历代儿童故事是什么意思
- I015384 福建少年英雄谱是什么意思
- I015385 洪湖赤子是什么意思
- I015398 扶我上战马的人是什么意思
- I015408 报童的故事是什么意思
- I015409 陈潭秋的故事是什么意思
- I015415 贺龙的脚印是什么意思
- I015417 《故事大王》选集是什么意思
- I015418 白居易的故事是什么意思
- I015422 张乐平爷爷的故事是什么意思
- I015423 谁像解放军是什么意思
- I015424 盗火者之歌是什么意思
- I015427 伟大的宋庆龄是什么意思
- I015428 故事与智力测验是什么意思
- I015429 孙敬修演讲故事大全是什么意思
- I015434 名人和他们的老师是什么意思
- I015435 我是小好奇是什么意思
- I015437 智力故事300个是什么意思
- I015440 大脑袋侦探长是什么意思
- I015444 郑和下西洋是什么意思
- I015445 杜甫的故事是什么意思
- I015446 中国历代笔记故事是什么意思
- I015447 猪八戒喝茶是什么意思
- I015449 苏东坡的故事是什么意思
- I015456 动物从军记是什么意思
- I015460 巍峨的泰山是什么意思
- I015467 小阿凡提的故事是什么意思
- I015471 中国历代名将故事是什么意思
- I015473 参天的大树是什么意思
- I015475 小萝卜头是什么意思
- I015478 中国古代医学家故事是什么意思
- I015482 少年聂荣臻是什么意思
- I015493 忽必烈的故事是什么意思
- I015495 达尔文环球探险记是什么意思
- I015496 徐霞客的故事是什么意思
- I015501 吉鸿昌的故事是什么意思
- I015509 世界名人故事是什么意思
- I015517 林汉达中国历史故事集是什么意思
- I015524 蒙古古代战斗故事是什么意思
- I015525 李自成的故事是什么意思
- I015527 苏轼的故事是什么意思